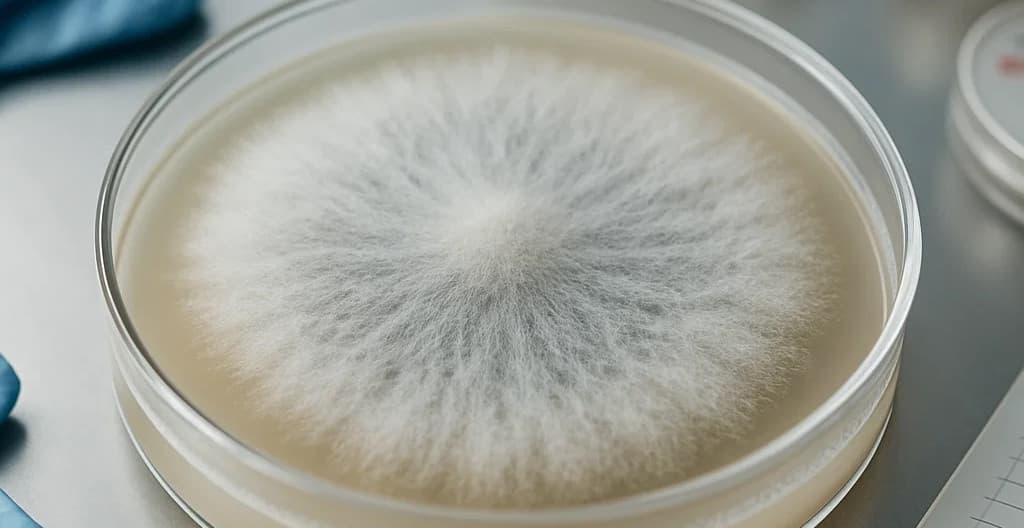
Saprolegnia Case

Engineer better feed additives. Better animal health.
Leverage our AI to generate feed additive candidates and improve your results. Develop better products and multiply your research.
Get a head start
Start your product development with a curated list of best candidates cutting your time-to-market
Better performance
Optimized for performance and production cost from day 0
Cut your development dycle in half
Every experiment sharpens our AI, unlocking smarter insights with each run.
Unlock new effects and ingredients
Explore off-the-radar sources and uncover breakthrough effects.
Case studies

Salmon Health
Design of natural fungicide
Tackling saprolegnia in salmon farming through intelligent molecular discovery.
Read case study
Salmon Health
Immunostimulant discovery
Precision immunostimulants: A molecular approach.
Read case studyLatest insights

Technical Review
CORAL AI: Hybrid Deep Learning for Drug Discovery
Discover how CORAL AI combines structural and sequence-based deep learning to accelerate molecular discovery across bioengineering applications.
Read case study